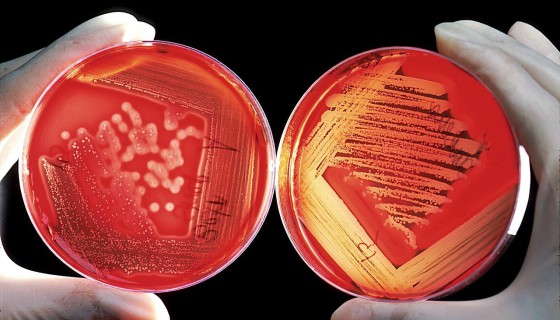
Mikrobiologia we Wrocławiu

Wrocław - uczelnie, kierunki, studia
Uczelnie we Wrocławiu
Uczelnie we Wrocławiu to tradycja, historia, renoma. Znajdują się tu praktycznie wszystkie typy szkół wyższych. We Wrocławiu studiować można na uniwersytecie, politechnice, uczelni ekonomicznej, przyrodniczej, medycznej, sportowej, wojskowej czy artystycznej, a także w jednej z wielu zlokalizowanych tu niepublicznych szkół wyższych. Oznacza to, że praktycznie wszystkie typy studiów dostępne są w stolicy Dolnego Śląska.
Poniżej zamieszczamy pełny wykaz uczelni oraz kierunków we Wrocławiu. Znajdziecie w nim dodatkowo informacje rekrutacyjne, szczegóły związane z naborem, a także opinie i komentarze studentów i przedstawicieli poszczególnych uczelni we Wrocławiu.
(+48) 665 866 669, 781 610 045, EN +48 71 784 17 53, +48 71 784 19 97
(+71) 325 15 14
(+71) 799 19 37
(+71) 333 11 07
Lokalizacja
Kierunki we Wrocławiu
Oferta studiów we Wrocławiu zadowoli kandydatów o różnorodnych i odmiennych zainteresowaniach. Dostępne są niemal wszystkie typy studiów, aczkolwiek najliczniej reprezentowane są kierunki filologiczne, inżynierskie oraz z obszaru nauk medycznych i ochrony zdrowia. Dużą grupę stanowi oferta kierunków artystycznych, projektowych.
Takie studia jak Militarioznawstwo, Dowodzenie, Medycyna roślin czy Weterynaria oprócz Wrocławia oferują nieliczne inne ośrodki akademickie.
Nie wiecie na co się zdecydować? Poniżej prezentujemy wykaz wszystkich kierunków studiów we Wrocławiu. W ich opisach znajdziecie m.in. informacje na temat rekrutacji, perspektyw zawodowych czy kierunków pokrewnych.
Kierunki studiów wg typów kształcenia
Studia we Wrocławiu
Specjalnie dla kandydatów na studia przygotowaliśmy serię artykułów, zawierających treści pomocne na etapie przystępowania do matury, wyboru ścieżki kształcenia, procedur rekrutacyjnych i samych studiów. Dowiecie się z nich m.in. jakie są dostępne typy studiów i kierunki we Wrocławiu i regionie, jak walczyć ze stresem egzaminacyjnym, jakie są najpopularniejsze studia, jak wygląda życie studenckie i rynek pracy we Wrocławiu, ile naprawę kosztują studia. Poniższe treści będą przydatne, gdy będziecie decydować, które uczelnie we Wrocławiu wybrać.
Zaciekawiła Was oferta kształcenia w tym regionie? Wybierzcie studia we Wrocławiu.
Informatyka we Wrocławiu

Elektronika we Wrocławiu

Aktorstwo we Wrocławiu

Studia dzienne czy studia zaoczne?

Biotechnologia we Wrocławiu

Lokum dla studenta

Ogrodnictwo we Wrocławiu

Sinologia we Wrocławiu

Studia chemiczne we Wrocławiu i woj. dolnośląskim

Kierunek lekarski i stomatologia we Wrocławiu

Studia ekonomiczne we Wrocławiu i na Dolnym Śląsku

Oblana matura, słabo zdana matura - co robić?

Matematyka we Wrocławiu

Logistyka we Wrocławiu

Europeistyka we Wrocławiu

ASP to mój dom

Studia sportowe we Wrocławiu i województwie dolnośląskim

Ekonomia we Wrocławiu

Automatyka i robotyka we Wrocławiu

Inżynieria biomedyczna we Wrocławiu

Studia teologiczne we Wrocławiu i woj. dolnośląskim

Jak walczyć z maturalnym stresem? Wskazówki dla maturzystów

Prawo we Wrocławiu

Życie studenckie we Wrocławiu

Najczęstsze błędy kandydatów przy wyborze studiów

Studia pedagogiczne we Wrocławiu i na Dolnym Śląsku

Turystyka we Wrocławiu

Studia społeczne we Wrocławiu i na Dolnym Śląsku

Budownictwo we Wrocławiu

Studia inżynierskie we Wrocławiu na Dolnym Śląsku

Zostałeś studentem i co dalej? - najczęstsze pytania pierwszoroczniaków

Studia geograficzne we Wrocławiu i woj. dolnośląskim

Pedagogika we Wrocławiu

Studia psychologiczne we Wrocławiu i na Dolnym Śląsku

Fizjoterapia we Wrocławiu

Ochrona środowiska we Wrocławiu

Kierunki sportowe na Dolnym Śląsku

Jaki kierunek studiów wybrać? - dylematy maturzysty

Studia prawnicze we Wrocławiu i woj. dolnośląskim

Gdzie i za ile mieszkać we Wrocławiu

Bioinformatyka we Wrocławiu

Studia historyczne we Wrocławiu i woj. dolnośląskim

Kryminologia we Wrocławiu

Studia wojskowe we Wrocławiu

Psychologia we Wrocławiu

Geoinformatyka we Wrocławiu

Studia filologiczne we Wrocławiu i na Dolnym Śląsku

Mikrobiologia we Wrocławiu
Dziennikarstwo we Wrocławiu

Studia turystyczne i hotelarskie we Wrocławiu i woj. dolnośląskim

Rolnictwo we Wrocławiu

Studia rolnicze i przyrodnicze we Wrocławiu i woj. dolnośląskim

Studia logistyczne we Wrocławiu i na Dolnym Śląsku

Stypendia dla studentów

Zimowy nabór na studia - jak wygląda rekrutacja w lutym?

Najpopularniejsze uczelnie w rekrutacji 2020_2021

Nie dostałeś się na wymarzone studia - co zrobić?

Rynek pracy we Wrocławiu

Lotnictwo i kosmonautyka we Wrocławiu

Farmacja we Wrocławiu

Mechatronika we Wrocławiu

Progi punktowe na studia

Inżynieria zarządzania we Wrocławiu

Studia matematyczne we Wrocławiu i województwie dolnośląskim

Ile naprawdę kosztują studia?

Kosmetologia we Wrocławiu

Studia architektoniczne we Wrocławiu i na Dolnym Śląsku

Energetyka we Wrocławiu

Bezpieczeństwo wewnętrzne i narodowe we Wrocławiu

Zootechnika we Wrocławiu

Studia informatyczne we Wrocławiu i na Dolnym Śląsku

Najczęściej wybierane uczelnie i kierunki podczas rekrutacji

Cyberbezpieczeństwo we Wrocławiu

Administracja we Wrocławiu

Zarządzanie we Wrocławiu

Chemia we Wrocławiu

Fizyka we Wrocławiu

Politologia we Wrocławiu

Studia dziennikarskie we Wrocławiu i na Dolnym Śląsku

Weterynaria we Wrocławiu

Studia aktorskie we Wrocławiu i woj. dolnośląskim

Studia artystyczne we Wrocławiu

Jakie studia wybrać?

Rekrutacja uzupełniająca na studia - wszystko o drugim naborze

Filologia angielska i filologia germańska we Wrocławiu

Bezpieczeństwo we Wrocławiu

Rekrutacja na studia, listy rezerwowe, brakujące punkty - poradnik

Architektura we Wrocławiu

Wrocław - informacje ogólne
Wrocław to najszybciej rozwijające się miasto Dolnego Śląska oraz jeden z największych ośrodków akademickich w kraju. To miasto stawiające na rozwój, nowoczesność, wysoką jakość życia, biznes. Wrocław przyciąga studentów różnorodną ofertą edukacyjną szkół wyższych oraz bogactwem miejsc wartych odwiedzenia.
Największe wrocławskie uczelnie publiczne to: Uniwersytet Wrocławski, Politechnika Wrocławska, Uniwersytet Ekonomiczny, Uniwersytet Przyrodniczy, Akademia Medyczna im. Piastów Śląskich, Akademia Wychowania Fizycznego, Akademia Sztuk Pięknych, Akademia Muzyczna im. Karola Lipińskiego, Akademia Wojsk Lądowych im. Gen. T. Kościuszki.
We Wrocławiu działa kilkanaście uczelni niepublicznych, które oferują studia ekonomiczne, medyczne, techniczne, filologiczne, turystyczne, artystyczne, humanistyczne, społeczne, prawno-administracyjne, sportowe, biologiczne, przyrodnicze.
Niezwykłe położenie Wrocławia między pięcioma rzekami czyni miasto czwartym w Europie pod względem liczby mostów. Jest ich ponad setka. Wrocław jest miastem kilku wysp. Najpopularniejsze z nich to: Wyspa Słodowa, Kępa Odrzańska, Wyspa Piasek, Wielka Wyspa. Miasto znane jest z Ogrodu Zoologicznego, posiadającego największą w Polsce liczbę gatunków zwierząt.
Zwiedzając Wrocław, warto obejrzeć: Stare Miasto z ratuszem, Piwnicę Świdnicką, Plac Solny czy pochodzący z początków XIII wieku Nowy Targ. Turystów i przyjezdnych studentów, z pewnością zachwyci także Pałac Królewski, Wrocławska Fontanna Multimedialna, Ogród Botaniczny, Stary Cmentarz Żydowski i Park Szczytnicki z Ogrodem Japońskim. Każdy obowiązkowo powinien obejrzeć słynną Panoramę Racławicką i przejść się reprezentacyjną ulicą Szewską.
We Wrocławiu prężnie działają teatry, opery, kluby, galerie, festiwale muzyczne. Gwarantują one doznania artystyczne na najwyższym poziomie i są najlepszą reklamą miasta. Dzięki temu Wrocław w pełni zasługuje na miano stolicy Dolnego Śląska i jest bardzo chętnie odwiedzany przez turystów z całego świata.
Najpopularniejsze przedsięwzięcia artystyczne we Wrocławiu to: Wratislavia Cantas, Przegląd Piosenki Aktorskiej, Dni Muzyki Starych Mistrzów, Szanty we Wrocławiu, Jazz nad Odrą, EuroDrama, Wrocław Non Stop, Festiwal ewentualnych Talentów Aktorskich - FeTA, Najnowsze Kino Polskie, czy SURVIVAL Przegląd Młodej Sztuki w ekstremalnych warunkach.
Wrocław może pochwalić się wieloma ośrodkami badawczymi i międzynarodowymi koncernami, jak: Whirpool, Hewlett-Packard, Volvo, Bosch, Siemens, Google, Toshiba, LG Philips, LG Electronics, US Pharmacia, i inne. Doskonale rozwija się tu sektor informatyczny oraz przemysł środków transportu, metalowy, elektroniczny.
Studenci z pewnością nie będą się nudzić we Wrocławiu. Miasto oferuje liczne imprezy dla młodego odbiorcy, koncerty muzyczne, kabarety, przeglądy filmowe.A wieczory wolne od nauki można spędzić w przytulnych knajpkach, pubach, kafejkach, dyskotekach, klubach muzycznych.
Typy studiów w Polsce






















































































































































